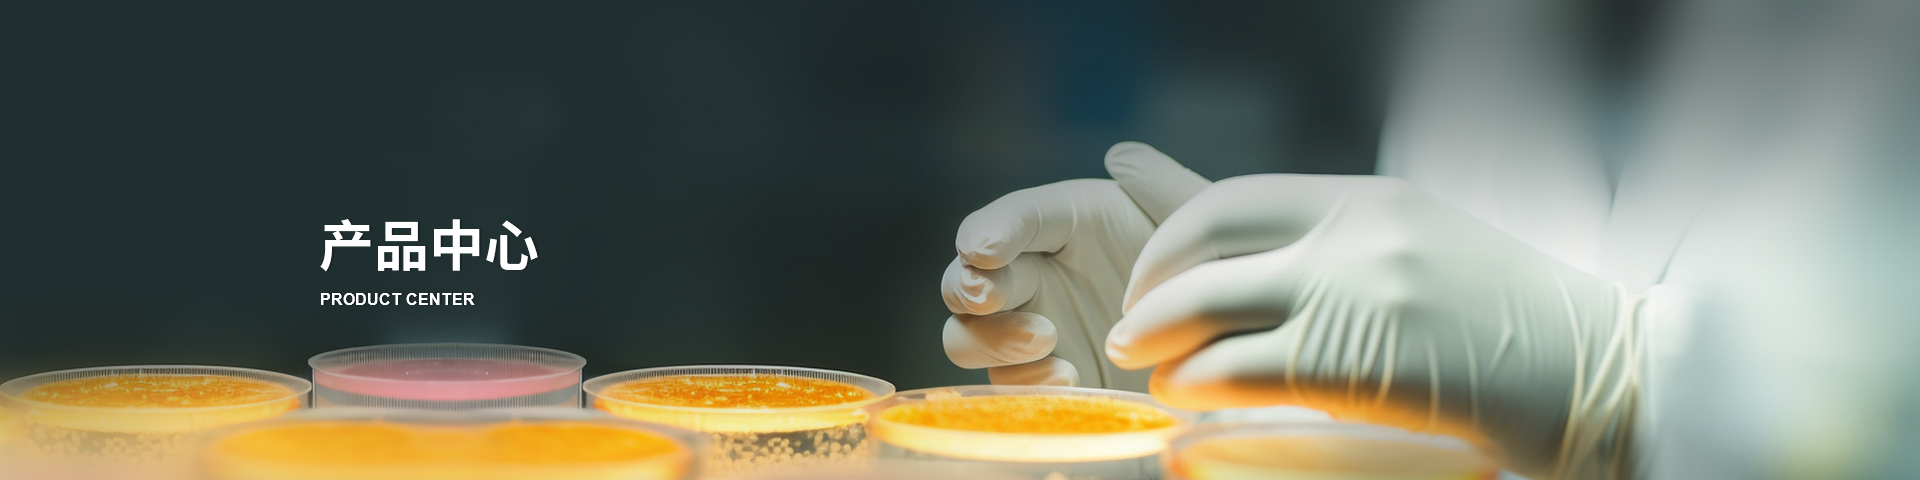
A549 ORGANOID

If you are having a hard time accessing the Atcc A549 page, Our website will help you. Find the right page for you to go to Atcc A549 down below. Our website provides the right place for Atcc A549.

https://es.ccm.net › ...
Si deseas borrar definitivamente una p gina de Facebook que creaste ya sea personal o comercial Meta para empresas primero debes ser administrador A continuaci n te ense amos a

https://es.ccm.net › ...
Si no deseas seguir teniendo una cuenta en Facebook la red social te da varias opciones borrarla para siempre eliminarla temporalmente o borrarla mediante un link Esto es

https://es.ccm.net › ... › redes-sociales-y-mensajeria
Facebook Parejas o Facebook Dating es el servicio de citas y encuentros de Facebook La red social tiene tanta informaci n sobre sus usuarios para bien y para mal que promete ser

https://es.ccm.net › ... › redes-sociales-y-mensajeria
Para utilizar Facebook es necesario registrarte antes y crear una cuenta personal en la red social El procedimiento es muy sencillo y lo detallamos en este art culo paso a paso Podr s

https://es.ccm.net › ... › redes-sociales-y-mensajeria
Facebook permite mantener el contacto con seres queridos Si necesitas encontrar a alguien ya sea un amigo o familiar puedes usar la herramienta de b squeda por nombre y apellido

https://es.ccm.net › ...
Si desactivaste temporalmente o eliminaste definitivamente tu cuenta en Facebook a n es posible recuperarla aunque depende de ciertos factores Te explicamos la diferencia entre

https://es.ccm.net › descargas › comunicacion
Con m s de 2 800 millones de usuarios activos al mes la red social m s grande del mundo te permite permanecer en contacto con amigos y familiares y volver a conectarte con
https://forums.commentcamarche.net › forum
Bonjour Il suffit de se rendre sur la page d accueil facebook de cliquer en restant appuy sur le logo Facebook en haut a gauche et de tout simplement faire glisser en restant toujours appuy bien

https://es.ccm.net › ...
Si no est s seguro de si olvidaste cerrar tu sesi n de Facebook en alg n dispositivo smartphone PC o tableta debes saber que puedes hacerlo de manera remota por ejemplo desde
Thank you for visiting this page to find the login page of Atcc A549 here. Hope you find what you are looking for!